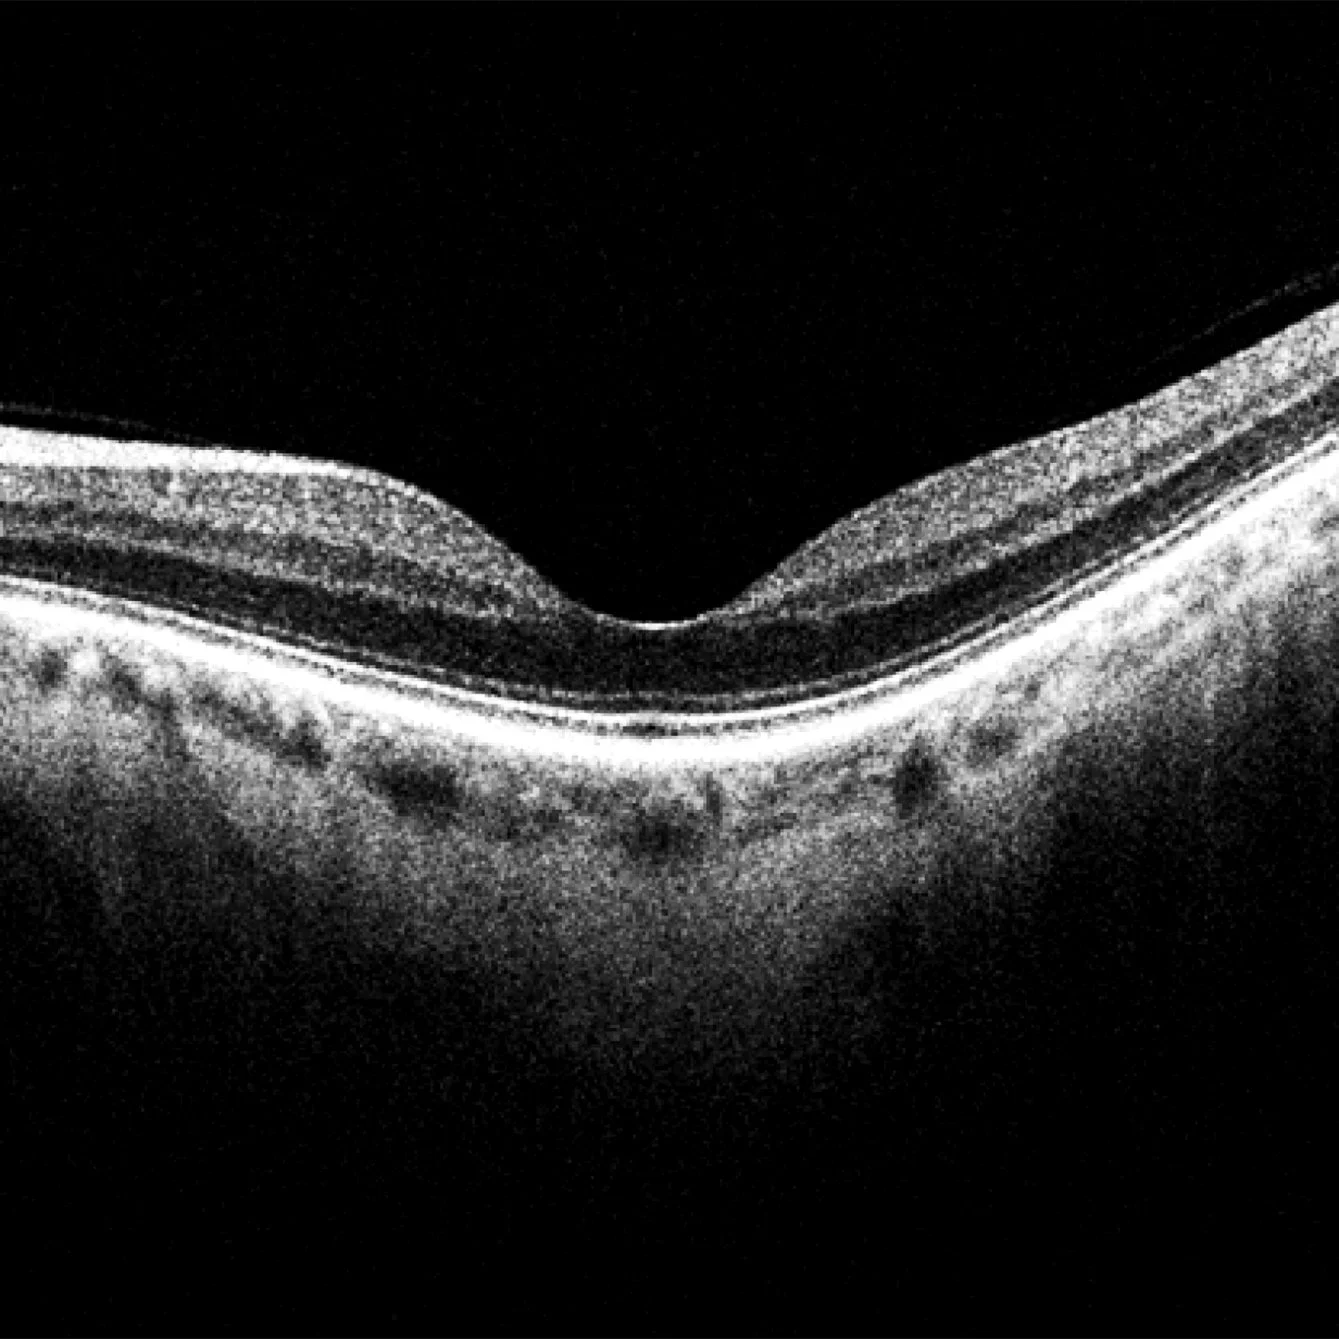

Estudios Oftalmológicos
Los estudios oftalmológicos son exámenes médicos especializados que se centran en la salud visual y el funcionamiento del sistema ocular. Estos procedimientos son cruciales para detectar y tratar una amplia gama de condiciones oculares, desde problemas refractivos comunes como la miopía, hipermetropía y astigmatismo, hasta enfermedades más serias como el glaucoma, la degeneración macular y las cataratas.
Estos estudios son fundamentales para mantener una buena salud visual y prevenir posibles complicaciones en el futuro. Es importante programar exámenes oftalmológicos regulares, especialmente para aquellos con antecedentes familiares de enfermedades oculares, diabetes u otras condiciones que puedan afectar la vista.
-

TOMOGRAFÍA DE NERVIO OPTICO Y CELULAS GANGLIONARES (OCT)
Estudio no invasivo que se utiliza para el diagnóstico de enfermedades del nervio óptico (glaucoma o alteraciones neuro oftalmológicas), o para seguimiento de la misma enfermedad.
-
TOMOGRAFÍA DE MACULA (OCT)
Estudio no invasivo que nos permite analizar el área de mejor visión, visión fina, visión a color (macula).
-

CAMPOS VISUALES
Estudio no invasivo que valora la vía visual desde que la luz entra al ojo hasta la formación de imágenes en el cerebro a través de estímulos luminosos. Nos ayuda para valorar si existe perdida visual en enfermedades como glaucoma, neuropatías ópticas, daño por medicamentos, traumatismos, etc.
-

ANGIOTOMOGRAFÍA DE MACULA
Estudio no invasivo que nos permite valorar la circulación del área de mejor visión, sin necesidad de usar medio de contraste ideal en paciente con alergia a fluoresceína, valorar enfermedades como membranas neovasculares entre otras.
-

ANGIOTOMOGRAFÍA DE NERVIO OPTICO
Estudio no invasivo que nos permite valorar la circulación de la cabeza del nervio óptico sin necesidad de usar medio de contraste, importante en enfermedades neurooftalmologicas, o inflamatorias del nervio.
-

PAQUIMETRÍA
Estudio no invasivo que mide el grosor de la córnea. Se utiliza como factor de riesgo para glaucoma.
-

TOMOGRAFÍA DE ANGULO
Estudio no invasivo que nos permite valorar la apertura angular, o lesiones que se encuentren en el ángulo.
-

TOMOGRAFÍA DE SEGMENTO ANTERIOR
Estudio no invasivo que nos permite valorar las capas de la córnea valorar si existe alguna lesión, valorar la profundidad de anillos intraestromales, o algún otro procedimiento realizado previamente.
-

FOTOGRAFÍA DE FONDO DE OJO
Estudio no invasivo realizado con un equipo especial que nos permite fotografiar la retina y el nervio óptico, valorar alteraciones o alguna lesión que presente el paciente.
-

ESTUDIO DE AUTOFLUORESCENCIA
Estudio diagnóstico no invasivo útil en el diagnóstico de enfermedades que afectan el fondo de ojo (nervio y mácula)
Tratamiento Laser
Contamos con YAG laser para realizar procedimientos como capsulotomía o iridotomías, así como tratamiento de trabeculoplastia laser selectiva. Estos procedimientos cuentan con sus indicaciones y cuidados sin embargo causa muy poca molestia al paciente. Este procedimiento se realiza siempre y cuando lo indique su médico tratante.
Consulta oftalmológica consta de una revisión minuciosa desde la graduación del paciente, así como toma de presión intraocular, gonioscopia, fundoscopia, biomicroscopia, todo esto con equipos de alta tecnología, así como médicos con alta especialidad para diagnosticar y tratar cualquier enfermedad de los ojos.